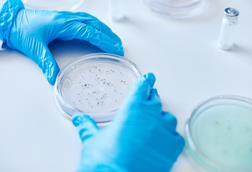
Close,Up,On,Unrecognizable,Microbiologist,Hands,In,Blue,Vinyl,Gloves

Quality, microbiology and contamination control
Access expert insights on pharmaceutical quality assurance, microbiology and contamination control, covering environmental monitoring, sterility, endotoxins, cleaning validation, risk management and testing strategies that safeguard product integrity and patient safety.
Webinars and whitepapers
- Previous
- Next
Quality, microbiology and contamination control
- Article
Day three preview: the Future of Bio/Pharma Analysis Virtual Summit 2026
Pharmaceutical manufacturing takes centre stage on Day three of The Future of Bio/Pharmaceutical Analysis Virtual Summit 2026 as speakers examine how digital technologies, artificial intelligence and advanced production methods are reshaping what is possible in the field.
- Article
From endotoxins to AI: what to expect at The Future of Bio/Pharmaceutical Analysis 2026
The Future of Bio/Pharmaceutical Analysis Virtual Summit returns 23–25 June 2026 with nine expert-led sessions covering environmental monitoring modernisation, non-animal endotoxin testing, nitrosamine compliance, regulatory disruption and AI-enabled digital transformation across the biopharma manufacturing landscape.
- Article
Selecting the right qPCR workflow strategy: task-based vs. full automation
Selecting the right qPCR workflow strategy: task-based vs. full automation
- Article
The shift towards strategic adoption of intelligent automation in pharmaceutical microbiology
Faced with increasing regulatory pressure and operational complexity, pharmaceutical manufacturers are rethinking the microbiology workflow. Intelligent automation is enabling a shift toward more consistent, scalable, and data-driven contamination control.
Unlock exclusive industry insights
- Bookmark articles and resources to access anytime
- Enjoy free access to industry leading resources, webinars and insights
- Stay informed with the latest news and breakthroughs in drug discovery
- Receive updates and recommendations tailored to your research interests
- Article
MultiNA II MCE-301: smarter nucleic acid analysis for the modern lab
Automation, precision, and sustainability – Shimadzu’s MultiNA II MCE-301 redefines microchip electrophoresis, delivering faster, greener, and more reliable DNA and RNA analysis for QA/QC and research laboratories alike.
- Article
How to choose the right microbial air sampler
Microbial monitoring is an essential step for complying with GMP regulations in aseptic pharmaceutical manufacturing. For air monitoring, active air samplers must efficiently collect viable particles and be validated according to EN 17141 or ISO 14698 requirements. Efficiency can be determined by flow rate accuracy and sampling time, which together ...
- Article
MAS-100 Libra®: Automated passive air sampling without air flow disturbance
The MAS-100 Libra® is an automated passive air sampling system for cleanrooms, combining reliable microbiological monitoring with preserved laminar air flow, while supporting continuous air monitoring in line with the Annex 1 (EudraLex 2022) requirement for critical areas.
- Application note
Smart manufacturing and beyond: the Tri-Integrity and the support to quality management maturity for Industry 4.0.
Quality management in Industry 4.0 is becoming more data-driven and integrated across the product lifecycle. However, fragmented systems and limited visibility continue to make consistent performance difficult.
- Application note
Robust, high-throughput automated solution for water endotoxin testing
Manual endotoxin testing workflows can introduce variability and restrict scalability in quality control laboratories. This application note examines how automated high-throughput systems address these challenges in water testing.
- Application note
Automating ion chromatography for reliable routine analysis
Routine ion chromatography workflows are often time-consuming and manual, making efficiency and consistency difficult to maintain. This application note explores how automation can simplify IC workflows and support more reliable routine analysis.
- Article
European Pharmaceutical Review Issue 1 (2026): Environmental Monitoring In-Depth Focus
This In-Depth Focus explores how BPCs, RMMs and AI-enabled analytics are being evaluated as a tool to enhance aseptic manufacturing, bioburden testing and monitoring.
- Article
From ‘What is it?’ to ‘What does it mean?’
A practical guide to interpreting microbial isolates during EMPQ and water system qualifications
- Article
European Pharmaceutical Review Issue 1 2026
EPR Issue 1 includes articles on manufacturing, drug delivery, environmental monitoring, analytical techniques and more.
- Article
TMSI: a novel, AI-driven alternative microbiological method for microorganism detection, enumeration and identification
Spore.Bio illustrates an AI-native, rapid microbiological method (RMM) that offers simultaneous viable quantitation and microbial identification capabilities suited to a range of applications including bioburden tests and environmental monitoring.
- Article
Optimising the downstream process in lentiviral vector manufacturing
Sartorius BIA Separations illustrates a promising alternative approach for efficient lentiviral vector purification that delivers a scalable, GMP-ready biomanufacturing solution.
- Article
Applying AI to enhance drug formulation and development
AI/ML is not replacing formulation scientists or process engineers; it is just amplifying their expertise.
- Article
European Pharmaceutical Review Issue 4 2025
EPR Issue 4 includes articles on manufacturing, AI/ML, vaccine development, biologics and more.
- Article
Optimising moisture and odour management in pharmaceutical packaging
This article answers some key questions about the need for environmental management in packaging, focusing on moisture and odour control, and the solutions available to achieve it.
- Article
Microbiology/RMM In-Depth Focus 2025
This in-depth focus features articles on rapid microbiological methods, quality control, and using AI to read agar plates.
- Article
Drug development In-Depth Focus 2025
From groundbreaking cell and gene therapies to cost-effective drug delivery innovations, Europe is emerging as a hub for life-changing therapies. Explore expert insights and innovative solutions shaping the pharmaceutical industry.
- Article
Guide to Outsourcing 2025
Doug Botkin, PhD Scientific Portfolio Specialist from Charles River Laboratories, examines how modern microbial ID tools can enhance contamination control strategies and the benefits an outsourcing partner can provide.
- Article
European Pharmaceutical Review Issue 3 2025
EPR Issue 3 includes articles on microbiology, downstream processing, manufacturing, drug formulation and more.
- Report
Pharma Horizons: leading-edge formulation
This report addresses the key factors shaping pharmaceutical formulation, including regulation, QC and analysis.
- Article
Advancing endotoxin testing with sustainable recombinant LAL solutions
Fujifilm Wako discusses its Pyrostar™ Neo+ reagent and reveals how recombinant technology is transforming endotoxin testing while addressing evolving industry demands.
- Article
Supporting the pharmaceutical industry – how a CDMO can help
After their recent webinar, European Pharmaceutical Review’s Head of Content Ian Betteridge spoke with the team at Adragos Pharma to discuss the role of a CDMO and their importance in the fill and finish sector.
- Article
A rapid microbiological method case study for advanced therapy medicinal products
In this article, Stacey Ramsey, Senior Manager – Microbial Applications Lab, Charles River Laboratories, discusses the modernisation of rapid microbiological methods (RMMs) and the potential of ATP-bioluminescence when testing cell-based products.
- Article
Guide to Testing 2025
In this Guide to Testing, articles explore method validation for endotoxin testing and using advanced chromatography solutions for analytical laboratory applications.
- Publication
European Pharmaceutical Review Issue 2 2025
EPR Issue 2 includes articles on the impact of tariffs on the pharmaceutical supply chain, advances in bioprocessing, manufacturing and more.